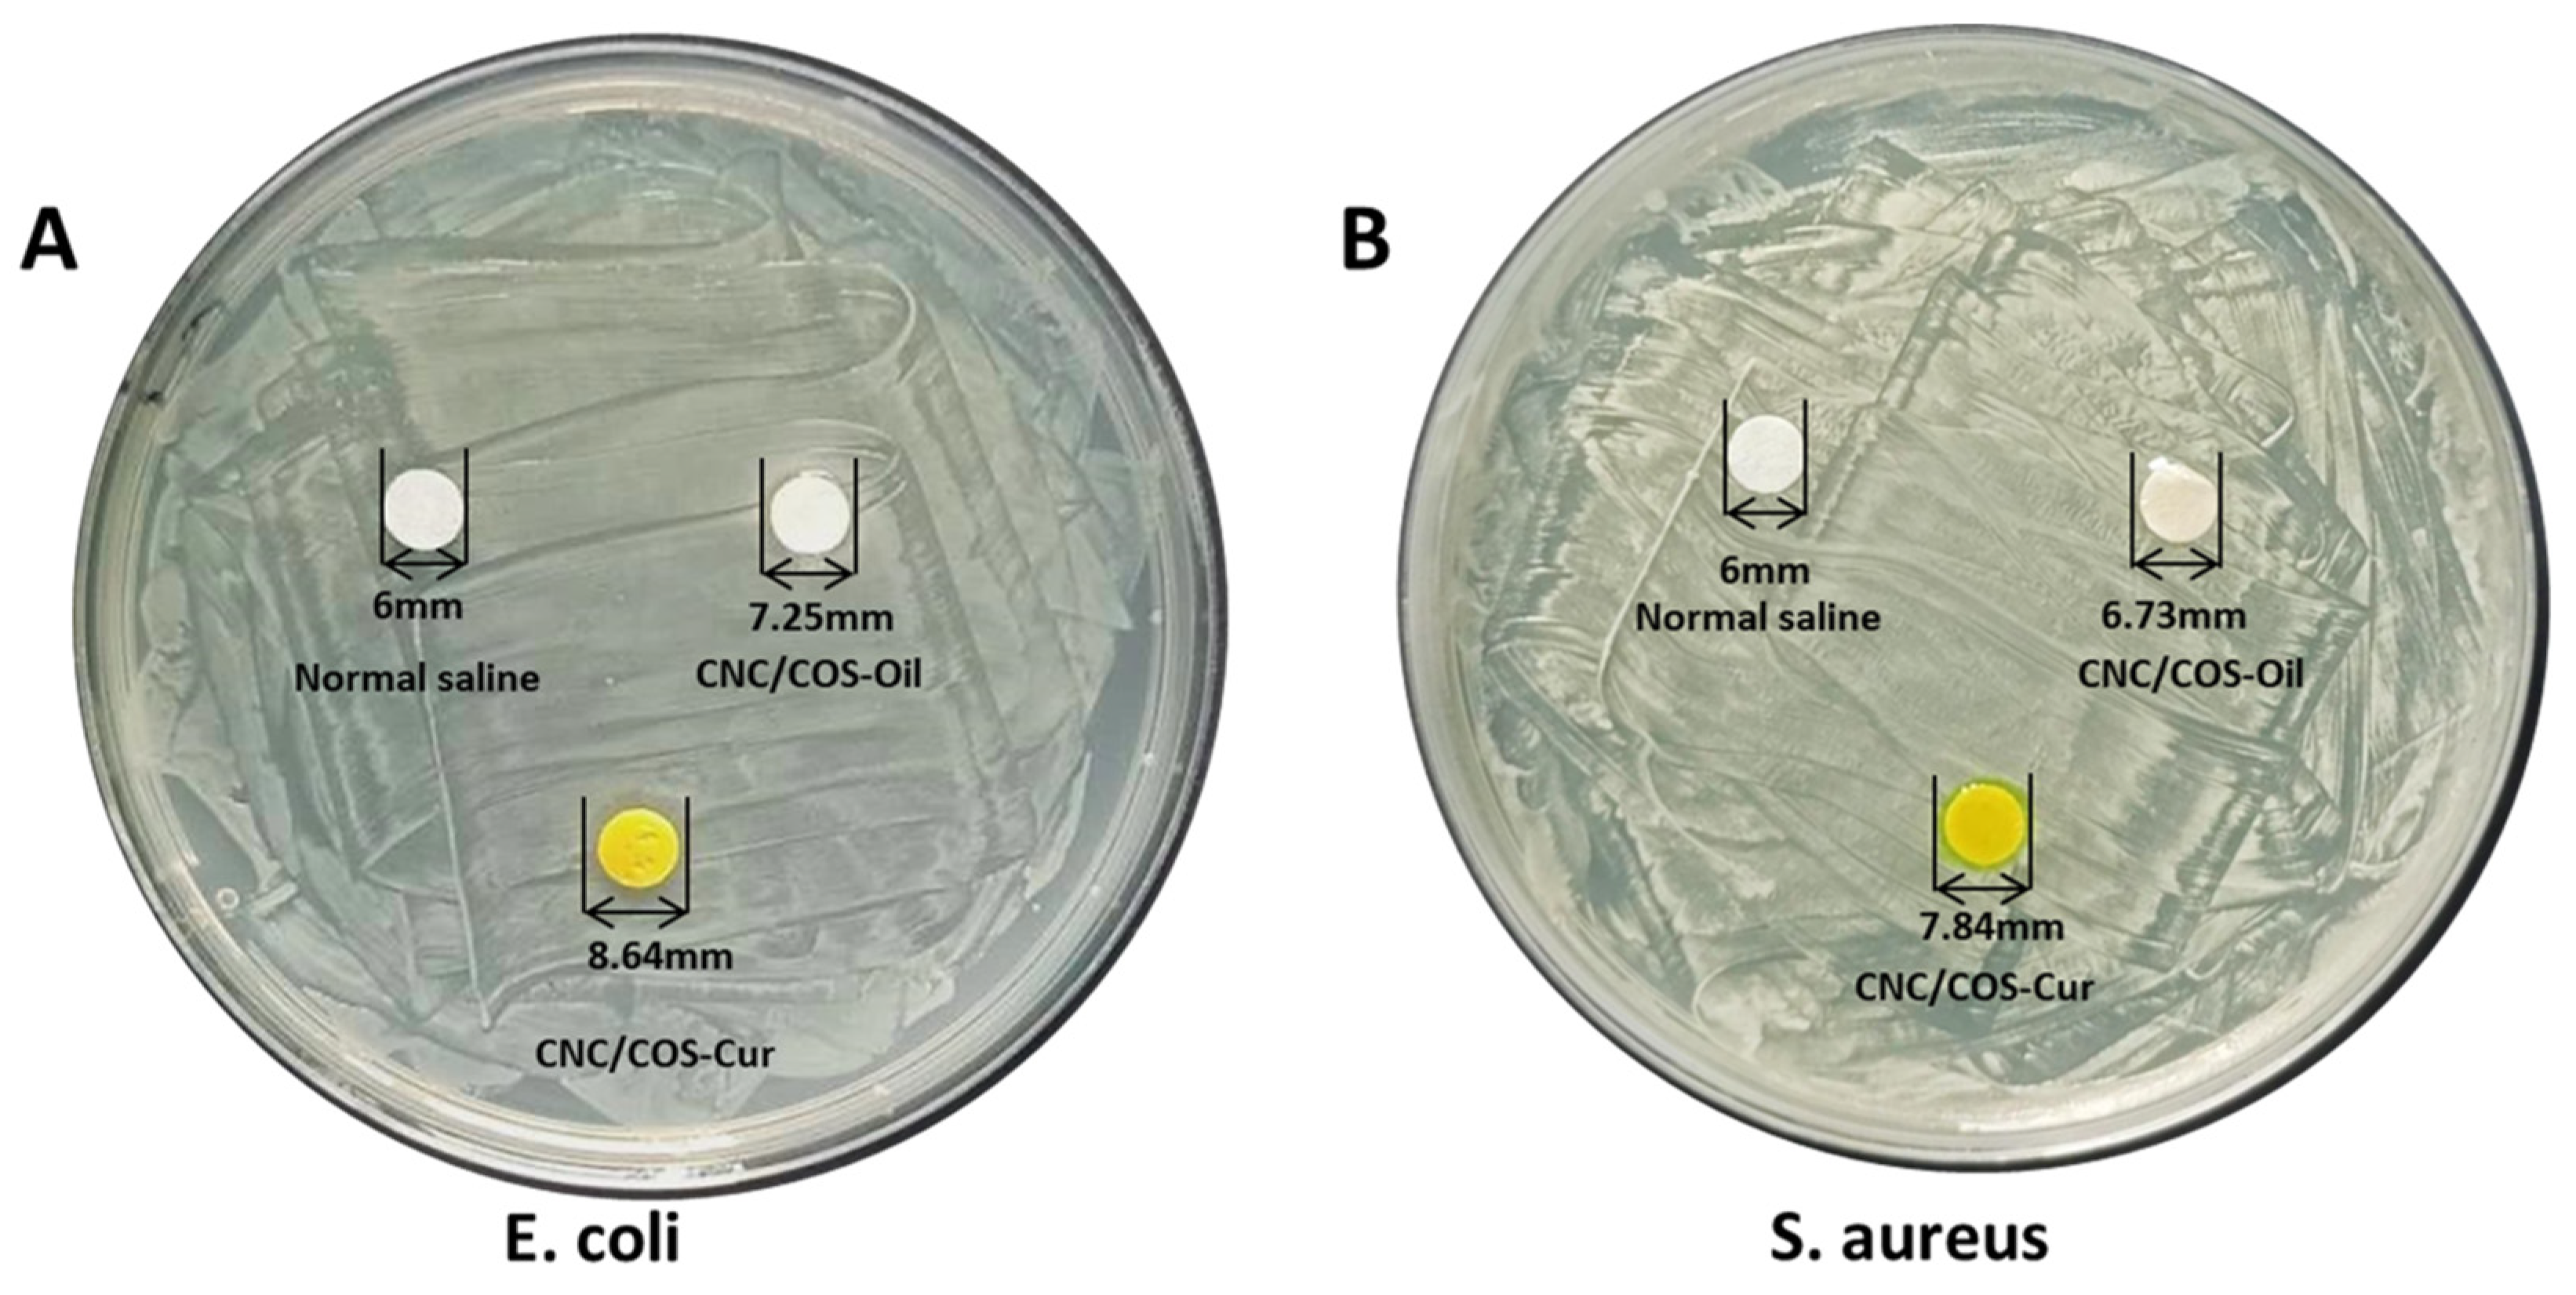
Pharmaceutics 16 01411 g008

Pickering Emulsion of Curcumin Stabilized by Cellulose Nanocrystals/Chitosan Oligosaccharide: Effect in Promoting Wound Healing
Abstract
1. Introduction
2. Materials and Methods
2.1. Materials
2.1.1. Chemicals
2.1.2. Animals
2.2. Methods
2.2.1. Preparation of the Aqueous Phase Supplemented with the CNC/COS Complex
2.2.2. Preparation of Cur Loaded Pickering Emulsion
2.2.3. Characterization of Cur Loaded Pickering Emulsion
Droplet Size and Zeta Potential Determination
Optical Microscopy of Cur-Loaded Pickering Emulsion
Confocal Laser-Scanning Microscope (CLSM)
Cryo-Scanning Electron Microscopy (Cryo-SEM)
2.2.4. Characterization of CNC/COS Complex
X-Ray Diffraction (XRD)
Fourier Transform Infrared (FTIR) Spectroscopy
Scanning Electron Microscopy (SEM)
2.2.5. Cur Contents in the Pickering Emulsion
Equipment and Chromatographic Conditions
Validation of the HPLC Method
Measurement of Cur Concentration
2.2.6. Short-Term Stability of Cur-Loaded Pickering Emulsion
2.2.7. Antioxidant Activity of Cur-Loaded Pickering Emulsion In Vitro
2.2.8. Release Profile of Cur from Pickering Emulsion In Vitro
2.2.9. Wound Healing In Vivo
Morphology of the Wounds
Biochemical Analysis
Histopathology
2.2.10. Antibacterial In Vitro
2.2.11. Statistical Analysis
3. Results and Discussion
3.1. Characterization of CNC–COS Complex
3.1.1. X-ray Diffraction (XRD)
3.1.2. Fourier Transform Infrared (FTIR) Spectroscopy
3.1.3. Scanning Electron Microscopy (SEM)
3.2. Characterization of Cur-Loaded Pickering Emulsion
3.2.1. Droplet Size and Zeta Potential Determination
3.2.2. Optical Microscopy of Pickering Emulsion of Cur
3.2.3. Confocal Laser-Scanning Microscope (CLSM)
3.2.4. Cryo-Scanning Electron Microscopy (Cryo-SEM)
3.3. Cur Contents in the Pickering Emulsion
3.4. Short Term Stability of Cur Loaded Pickering Emulsion
3.5. Antioxidant Activity In Vitro of Cur Loaded Pickering Emulsion
3.6. In Vitro Release Profile of Cur from Pickering Emulsion
3.7. In Vivo Wound Healing
3.7.1. Morphology of the Wounds
3.7.2. Histopathology
3.7.3. Biochemical Analysis
3.8. In Vitro Antibacterial
3.9. Conclusions
Author Contributions
Funding
Institutional Review Board Statement
Informed Consent Statement
Data Availability Statement
Acknowledgments
Conflicts of Interest
References
- Chen, L.; Ao, F.; Ge, X.; Shen, W. Food-Grade Pickering Emulsions: Preparation, Stabilization and Applications. Molecules 2020, 25, 3202. [Google Scholar] [CrossRef] [PubMed]
- Peito, S.; Peixoto, D.; Ferreira-Faria, I.; Margarida Martins, A.; Margarida Ribeiro, H.; Veiga, F.; Marto, J.; Cláudia Paiva-Santos, A. Nano- and microparticle-stabilized Pickering emulsions designed for topical therapeutics and cosmetic applications. Int. J. Pharm. 2022, 615, 121455. [Google Scholar] [CrossRef] [PubMed]
- Li, W.; Jiao, B.; Li, S.; Faisal, S.; Shi, A.; Fu, W.; Chen, Y.; Wang, Q. Recent Advances on Pickering Emulsions Stabilized by Diverse Edible Particles: Stability Mechanism and Applications. Front. Nutr. 2022, 9, 864943. [Google Scholar] [CrossRef] [PubMed]
- Li, C.; Luo, X.; Li, L.; Cai, Y.; Kang, X.; Li, P. Carboxymethyl chitosan-based electrospun nanofibers with high citral-loading for potential anti-infection wound dressings. Int. J. Biol. Macromol. 2022, 209, 344–355. [Google Scholar] [CrossRef] [PubMed]
- Asfour, M.H.; Elmotasem, H.; Mostafa, D.M.; Salama, A.A.A. Chitosan based Pickering emulsion as a promising approach for topical application of rutin in a solubilized form intended for wound healing: In vitro and in vivo study. Int. J. Pharm. 2017, 534, 325–338. [Google Scholar] [CrossRef]
- Wu, X.; Zhang, Q.; Wang, Z.; Xu, Y.; Tao, Q.; Wang, J.; Kong, X.; Sheng, K.; Wang, Y. Investigation of construction and characterization of carboxymethyl chitosan—Sodium alginate nanoparticles to stabilize Pickering emulsion hydrogels for curcumin encapsulation and accelerating wound healing. Int. J. Biol. Macromol. 2022, 209, 1837–1847. [Google Scholar] [CrossRef]
- Milcovich, G.; Antunes, F.E.; Farra, R.; Grassi, G.; Grassi, M.; Asaro, F. Modulating carbohydrate-based hydrogels as viscoelastic lubricant substitute for articular cartilages. Int. J. Biol. Macromol. 2017, 102, 796–804. [Google Scholar] [CrossRef]
- Goswami, A.; Alam, K.M.; Kumar, P.; Kar, P.; Thundat, T.; Shankar, K. Mapping the surface potential, charge density and adhesion of cellulose nanocrystals using advanced scanning probe microscopy. Carbohydr. Polym. 2020, 246, 116393. [Google Scholar] [CrossRef]
- Tang, C.; Spinney, S.; Shi, Z.; Tang, J.; Peng, B.; Luo, J.; Tam, K.C. Amphiphilic Cellulose Nanocrystals for Enhanced Pickering Emulsion Stabilization. Langmuir 2018, 34, 12897–12905. [Google Scholar] [CrossRef]
- Cherhal, F.; Cousin, F.; Capron, I. Influence of charge density and ionic strength on the aggregation process of cellulose nanocrystals in aqueous suspension, as revealed by small-angle neutron scattering. Langmuir 2015, 31, 5596–5602. [Google Scholar] [CrossRef]
- Jung, W.J.; Park, R.D. Bioproduction of chitooligosaccharides: Present and perspectives. Mar. Drugs 2014, 12, 5328–5356. [Google Scholar] [CrossRef] [PubMed]
- Yang, F.; Luan, B.; Sun, Z.; Yang, C.; Yu, Z.; Li, X. Application of chitooligosaccharides as antioxidants in beer to improve the flavour stability by protecting against beer staling during storage. Biotechnol. Lett. 2017, 39, 305–310. [Google Scholar] [CrossRef] [PubMed]
- Yang, J.W.; Tian, G.; Chen, D.W.; Yao, Y.; He, J.; Zheng, P.; Mao, X.B.; Yu, J.; Huang, Z.Q.; Yu, B. Involvement of PKA signalling in anti-inflammatory effects of chitosan oligosaccharides in IPEC-J2 porcine epithelial cells. J. Anim. Physiol. Anim. Nutr. 2018, 102, 252–259. [Google Scholar] [CrossRef]
- Vanneman, M.; Dranoff, G. Combining immunotherapy and targeted therapies in cancer treatment. Nat. Rev. Cancer 2012, 12, 237–251. [Google Scholar] [CrossRef]
- Sandri, G.; Aguzzi, C.; Rossi, S.; Bonferoni, M.C.; Bruni, G.; Boselli, C.; Cornaglia, A.I.; Riva, F.; Viseras, C.; Caramella, C.; et al. Halloysite and chitosan oligosaccharide nanocomposite for wound healing. Acta Biomater. 2017, 57, 216–224. [Google Scholar] [CrossRef]
- Yue, L.; Sun, D.; Mahmood Khan, I.; Liu, X.; Jiang, Q.; Xia, W. Cinnamyl alcohol modified chitosan oligosaccharide for enhancing antimicrobial activity. Food Chem. 2020, 309, 125513. [Google Scholar] [CrossRef] [PubMed]
- Caetano, L.A.; Almeida, A.J.; Goncalves, L.M. Effect of Experimental Parameters on Alginate/Chitosan Microparticles for BCG Encapsulation. Mar. Drugs 2016, 14, 90. [Google Scholar] [CrossRef]
- Fang, L.; Lin, H.; Wu, Z.; Wang, Z.; Fan, X.; Cheng, Z.; Hou, X.; Chen, D. In vitro/vivo evaluation of novel mitochondrial targeting charge-reversal polysaccharide-based antitumor nanoparticle. Carbohydr. Polym. 2020, 234, 115930. [Google Scholar] [CrossRef]
- Liu, X.; Huang, H.; Liu, G.; Zhou, W.; Chen, Y.; Jin, Q.; Ji, J. Multidentate zwitterionic chitosan oligosaccharide modified gold nanoparticles: Stability, biocompatibility and cell interactions. Nanoscale 2013, 5, 3982–3991. [Google Scholar] [CrossRef]
- Lee, J.Y.; Termsarasab, U.; Lee, M.Y.; Kim, D.H.; Lee, S.Y.; Kim, J.S.; Cho, H.J.; Kim, D.D. Chemosensitizing indomethacin-conjugated chitosan oligosaccharide nanoparticles for tumor-targeted drug delivery. Acta Biomater. 2017, 57, 262–273. [Google Scholar] [CrossRef]
- Azuma, K.; Osaki, T.; Kurozumi, S.; Kiyose, M.; Tsuka, T.; Murahata, Y.; Imagawa, T.; Itoh, N.; Minami, S.; Sato, K.; et al. Anti-inflammatory effects of orally administered glucosamine oligomer in an experimental model of inflammatory bowel disease. Carbohydr. Polym. 2015, 115, 448–456. [Google Scholar] [CrossRef] [PubMed]
- Wang, Y.; Khan, A.; Liu, Y.; Feng, J.; Dai, L.; Wang, G.; Alam, N.; Tong, L.; Ni, Y. Chitosan oligosaccharide-based dual pH responsive nano-micelles for targeted delivery of hydrophobic drugs. Carbohydr. Polym. 2019, 223, 115061. [Google Scholar] [CrossRef]
- Zhang, J.; Han, J.; Zhang, X.; Jiang, J.; Xu, M.; Zhang, D.; Han, J. Polymeric nanoparticles based on chitooligosaccharide as drug carriers for co-delivery of all-trans-retinoic acid and paclitaxel. Carbohydr. Polym. 2015, 129, 25–34. [Google Scholar] [CrossRef] [PubMed]
- Zhao, Y.; Zheng, C.; Zhang, L.; Chen, Y.; Ye, Y.; Zhao, M. Knockdown of STAT3 expression in SKOV3 cells by biodegradable siRNA-PLGA/CSO conjugate micelles. Colloids Surf. B Biointerfaces 2015, 127, 155–163. [Google Scholar] [CrossRef]
- Liu, Z.; Hu, M.; Zhang, S.; Jiang, L.; Xie, F.; Li, Y. Oil-in-water Pickering emulsion stabilization with oppositely charged polysaccharide particles: Chitin nanocrystals/fucoidan complexes. J. Sci. Food Agric. 2021, 101, 3003–3012. [Google Scholar] [CrossRef]
- Tao, S.; Jiang, H.; Gong, S.; Yin, S.; Li, Y.; Ngai, T. Pickering Emulsions Simultaneously Stabilized by Starch Nanocrystals and Zein Nanoparticles: Fabrication, Characterization, and Application. Langmuir 2021, 37, 8577–8584. [Google Scholar] [CrossRef] [PubMed]
- Mohanty, C.; Das, M.; Sahoo, S.K. Emerging role of nanocarriers to increase the solubility and bioavailability of curcumin. Expert Opin. Drug Deliv. 2012, 9, 1347–1364. [Google Scholar] [CrossRef] [PubMed]
- Sidhu, G.S.; Mani, H.; Gaddipati, J.P.; Singh, A.K.; Seth, P.; Banaudha, K.K.; Patnaik, G.K.; Maheshwari, R.K. Curcumin enhances wound healing in streptozotocin induced diabetic rats and genetically diabetic mice. Wound Repair Regen. 1999, 7, 362–374. [Google Scholar] [CrossRef]
- Sidhu, G.S.; Singh, A.K.; Thaloor, D.; Banaudha, K.K.; Patnaik, G.K.; Srimal, R.C.; Maheshwari, R.K. Enhancement of wound healing by curcumin in animals. Wound Repair Regen. 1998, 6, 167–177. [Google Scholar] [CrossRef]
- Zhao, R.; Yang, B.; Wang, L.; Xue, P.; Deng, B.; Zhang, G.; Jiang, S.; Zhang, M.; Liu, M.; Pi, J.; et al. Curcumin protects human keratinocytes against inorganic arsenite-induced acute cytotoxicity through an NRF2-dependent mechanism. Oxid. Med. Cell. Longev. 2013, 2013, 412576. [Google Scholar] [CrossRef]
- Bahrani, S.; Ghaedi, M.; Khoshnood Mansoorkhani, M.J.; Ostovan, A. A highly selective nanocomposite based on MIP for curcumin trace levels quantification in food samples and human plasma following optimization by central composite design. J. Chromatogr. B Analyt. Technol. Biomed. Life Sci. 2017, 1040, 129–135. [Google Scholar] [CrossRef] [PubMed]
- Han, J.; Chen, F.; Gao, C.; Zhang, Y.; Tang, X. Environmental stability and curcumin release properties of Pickering emulsion stabilized by chitosan/gum arabic nanoparticles. Int. J. Biol. Macromol. 2020, 157, 202–211. [Google Scholar] [CrossRef] [PubMed]
- Carpenter, J.; George, S.; Saharan, V.K. Curcumin Encapsulation in Multilayer Oil-in-Water Emulsion: Synthesis Using Ultrasonication and Studies on Stability and Antioxidant and Release Activities. Langmuir 2019, 35, 10866–10876. [Google Scholar] [CrossRef] [PubMed]
- Joung, H.J.; Choi, M.J.; Kim, J.T.; Park, S.H.; Park, H.J.; Shin, G.H. Development of Food-Grade Curcumin Nanoemulsion and its Potential Application to Food Beverage System: Antioxidant Property and In Vitro Digestion. J. Food Sci. 2016, 81, N745–N753. [Google Scholar] [CrossRef]
- Li, X.; Ye, X.; Qi, J.; Fan, R.; Gao, X.; Wu, Y.; Zhou, L.; Tong, A.; Guo, G. EGF and curcumin co-encapsulated nanoparticle/hydrogel system as potent skin regeneration agent. Int. J. Nanomed. 2016, 11, 3993–4009. [Google Scholar] [CrossRef]
- Wang, X.Y.; Heuzey, M.C. Chitosan-Based Conventional and Pickering Emulsions with Long-Term Stability. Langmuir 2016, 32, 929–936. [Google Scholar] [CrossRef]
- Zhang, H.; Chen, Y.; Wang, S.; Ma, L.; Yu, Y.; Dai, H.; Zhang, Y. Extraction and comparison of cellulose nanocrystals from lemon (Citrus limon) seeds using sulfuric acid hydrolysis and oxidation methods. Carbohydr. Polym. 2020, 238, 116180. [Google Scholar] [CrossRef]
- Low, L.E.; Siva, S.P.; Ho, Y.K.; Chan, E.S.; Tey, B.T. Recent advances of characterization techniques for the formation, physical properties and stability of Pickering emulsion. Adv. Colloid Interface Sci. 2020, 277, 102117. [Google Scholar] [CrossRef] [PubMed]
- Matos, M.; Marefati, A.; Bordes, R.; Gutiérrez, G.; Rayner, M. Combined emulsifying capacity of polysaccharide particles of different size and shape. Carbohydr. Polym. 2017, 169, 127–138. [Google Scholar] [CrossRef]
- Zhou, Y.; Sun, S.; Bei, W.; Zahi, M.R.; Yuan, Q.; Liang, H. Preparation and antimicrobial activity of oregano essential oil Pickering emulsion stabilized by cellulose nanocrystals. Int. J. Biol. Macromol. 2018, 112, 7–13. [Google Scholar] [CrossRef]
- Bao, Y.; Xue, H.; Yue, Y.; Wang, X.; Yu, H.; Piao, C. Preparation and Characterization of Pickering Emulsions with Modified Okara Insoluble Dietary Fiber. Foods 2021, 10, 2982. [Google Scholar] [CrossRef] [PubMed]
- Laquerbe, S.; Carvalho, A.; Schmutz, M.; Poirier, A.; Baccile, N.; Ben Messaoud, G. pH-switchable pickering emulsions stabilized by polyelectrolyte-biosurfactant complex coacervate colloids. J. Colloid Interface Sci. 2021, 600, 23–36. [Google Scholar] [CrossRef] [PubMed]
- Kim, S.Y.; Kim, E.A.; Kim, Y.S.; Yu, S.K.; Choi, C.; Lee, J.S.; Kim, Y.T.; Nah, J.W.; Jeon, Y.J. Protective effects of polysaccharides from Psidium guajava leaves against oxidative stresses. Int. J. Biol. Macromol. 2016, 91, 804–811. [Google Scholar] [CrossRef] [PubMed]
- Feng, X.; Bie, N.; Li, J.; Zhang, M.; Feng, Y.; Ding, T.; Zhao, Y.; Wang, C. Effect of in vitro simulated gastrointestinal digestion on the antioxidant activity, molecular weight, and microstructure of polysaccharides from Chinese yam. Int. J. Biol. Macromol. 2022, 207, 873–882. [Google Scholar] [CrossRef]
- Alshehab, M.; Nitin, N. Encapsulation and release of curcumin using an intact milk fat globule delivery system. Food Funct. 2019, 10, 7121–7130. [Google Scholar] [CrossRef]
- McClements, D.J.; Öztürk, B. Utilization of Nanotechnology to Improve the Handling, Storage and Biocompatibility of Bioactive Lipids in Food Applications. Foods 2021, 10, 365. [Google Scholar] [CrossRef]
- Liang, G.; Yang, S.; Zhou, H.; Shao, L.; Huang, K.; Xiao, J.; Huang, Z.; Li, X. Synthesis, crystal structure and anti-inflammatory properties of curcumin analogues. Eur. J. Med. Chem. 2009, 44, 915–919. [Google Scholar] [CrossRef]
- Lima, C.F.; Pereira-Wilson, C.; Rattan, S.I. Curcumin induces heme oxygenase-1 in normal human skin fibroblasts through redox signaling: Relevance for anti-aging intervention. Mol. Nutr. Food Res. 2011, 55, 430–442. [Google Scholar] [CrossRef]
- Gunes, H.; Gulen, D.; Mutlu, R.; Gumus, A.; Tas, T.; Topkaya, A.E. Antibacterial effects of curcumin: An in vitro minimum inhibitory concentration study. Toxicol. Ind. Health 2016, 32, 246–250. [Google Scholar] [CrossRef]
- Kianvash, N.; Bahador, A.; Pourhajibagher, M.; Ghafari, H.; Nikoui, V.; Rezayat, S.M.; Dehpour, A.R.; Partoazar, A. Evaluation of propylene glycol nanoliposomes containing curcumin on burn wound model in rat: Biocompatibility, wound healing, and anti-bacterial effects. Drug Deliv. Transl. Res. 2017, 7, 654–663. [Google Scholar] [CrossRef]
- Rathinavel, S.; Korrapati, P.S.; Kalaiselvi, P.; Dharmalingam, S. Mesoporous silica incorporated PCL/Curcumin nanofiber for wound healing application. Eur. J. Pharm. Sci. 2021, 167, 106021. [Google Scholar] [CrossRef] [PubMed]
- Kulac, M.; Aktas, C.; Tulubas, F.; Uygur, R.; Kanter, M.; Erboga, M.; Ceber, M.; Topcu, B.; Ozen, O.A. The effects of topical treatment with curcumin on burn wound healing in rats. J. Mol. Histol. 2013, 44, 83–90. [Google Scholar] [CrossRef] [PubMed]
- Čoma, M.; Fröhlichová, L.; Urban, L.; Zajíček, R.; Urban, T.; Szabo, P.; Novák, Š.; Fetissov, V.; Dvořánková, B.; Smetana, K., Jr.; et al. Molecular Changes Underlying Hypertrophic Scarring following Burns Involve Specific Deregulations at All Wound Healing Stages (Inflammation, Proliferation and Maturation). Int. J. Mol. Sci. 2021, 22, 897. [Google Scholar] [CrossRef]
- Rai, A.; Ferrão, R.; Marta, D.; Vilaça, A.; Lino, M.; Rondão, T.; Ji, J.; Paiva, A.; Ferreira, L. Antimicrobial Peptide-Tether Dressing Able to Enhance Wound Healing by Tissue Contact. ACS Appl. Mater. Interfaces 2022, 14, 24213–24228. [Google Scholar] [CrossRef]
- Wang, C.; Wang, M.; Xu, T.; Zhang, X.; Lin, C.; Gao, W.; Xu, H.; Lei, B.; Mao, C. Engineering Bioactive Self-Healing Antibacterial Exosomes Hydrogel for Promoting Chronic Diabetic Wound Healing and Complete Skin Regeneration. Theranostics 2019, 9, 65–76. [Google Scholar] [CrossRef] [PubMed]
- Clark, R.A. Biology of dermal wound repair. Dermatol. Clin. 1993, 11, 647–666. [Google Scholar] [CrossRef]
- Lu, Y.S.; Jiang, Y.; Yuan, J.P.; Jiang, S.B.; Yang, Y.; Zhu, P.Y.; Sun, Y.Z.; Qi, R.Q.; Liu, T.; Wang, H.X.; et al. UVA Induced Oxidative Stress Was Inhibited by Paeoniflorin/Nrf2 Signaling or PLIN2. Front. Pharmacol. 2020, 11, 736. [Google Scholar] [CrossRef]
- Arican, O.; Ozturk, P.; Kurutas, E.B.; Unsal, V. Status of oxidative stress on lesional skin surface of plantar warts. J. Eur. Acad. Dermatol. Venereol. JEADV 2013, 27, 365–369. [Google Scholar] [CrossRef]
- Cui, B.; Wang, Y.; Jin, J.; Yang, Z.; Guo, R.; Li, X.; Yang, L.; Li, Z. Resveratrol Treats UVB-Induced Photoaging by Anti-MMP Expression, through Anti-Inflammatory, Antioxidant, and Antiapoptotic Properties, and Treats Photoaging by Upregulating VEGF-B Expression. Oxid. Med. Cell. Longev. 2022, 2022, 6037303. [Google Scholar] [CrossRef]
- Paprocki, J.; Pawłowska, M.; Sutkowy, P.; Piechocki, J.; Woźniak, A. Evaluation of Oxidative Stress in Patients with Difficult-to-Heal Skin Wounds Treated with Hyperbaric Oxygen. Oxid. Med. Cell. Longev. 2020, 2020, 1835352. [Google Scholar] [CrossRef]
- Mahmood, S.; Bhattarai, P.; Khan, N.R.; Subhan, Z.; Razaque, G.; Albarqi, H.A.; Alqahtani, A.A.; Alasiri, A.; Zhu, L. An Investigation for Skin Tissue Regeneration Enhancement/Augmentation by Curcumin-Loaded Self-Emulsifying Drug Delivery System (SEDDS). Polymers 2022, 14, 2904. [Google Scholar] [CrossRef] [PubMed]
- Chen, K.; Pan, H.; Ji, D.; Li, Y.; Duan, H.; Pan, W. Curcumin-loaded sandwich-like nanofibrous membrane prepared by electrospinning technology as wound dressing for accelerate wound healing. Mater. Sci. Eng. C Mater. Biol. Appl. 2021, 127, 112245. [Google Scholar] [CrossRef] [PubMed]
- Saranya, T.S.; Rajan, V.K.; Biswas, R.; Jayakumar, R.; Sathianarayanan, S. Synthesis, characterisation and biomedical applications of curcumin conjugated chitosan microspheres. Int. J. Biol. Macromol. 2018, 110, 227–233. [Google Scholar] [CrossRef] [PubMed]
- Zhang, J.; Zhang, H.; Liu, L.; Chen, Z. Emulsions stabilized by cellulose-based nanoparticles for curcumin encapsulations: In vitro antioxidant properties. Front. Nutr. 2022, 9, 931581. [Google Scholar] [CrossRef]

| Linearity Range, μg/mL | Coefficient of Determination (r2) | Regression Equations | Repeatability, RSD% |
|---|---|---|---|
| 0.502–200.8 | 0.9998 | Y = 0.0352X + 0.0395 | 0.14 |
| Percentage recoveries/%, RSD/% | Precision, RSD, % | LOD, μg/mL | LOQ, μg/mL |
| 100.3%, 0.12% | 0.34% | 0.40 | 1.02 |
| Control | CNC/COS–Oil | CNC/COS–Cur | |
|---|---|---|---|
| E. coli | — | 7.23 ± 0.47 mm | 8.56 ± 0.33 mm |
| S. aureus | — | 6.94 ± 0.29 mm | 7.59 ± 0.22 mm |
Disclaimer/Publisher’s Note: The statements, opinions and data contained in all publications are solely those of the individual author(s) and contributor(s) and not of MDPI and/or the editor(s). MDPI and/or the editor(s) disclaim responsibility for any injury to people or property resulting from any ideas, methods, instructions or products referred to in the content. |
© 2024 by the authors. Licensee MDPI, Basel, Switzerland. This article is an open access article distributed under the terms and conditions of the Creative Commons Attribution (CC BY) license (https://creativecommons.org/licenses/by/4.0/).
Share and Cite
Xie, L.; Dai, X.; Li, Y.; Cao, Y.; Shi, M.; Li, X. Pickering Emulsion of Curcumin Stabilized by Cellulose Nanocrystals/Chitosan Oligosaccharide: Effect in Promoting Wound Healing. Pharmaceutics 2024, 16, 1411. https://doi.org/10.3390/pharmaceutics16111411
Xie L, Dai X, Li Y, Cao Y, Shi M, Li X. Pickering Emulsion of Curcumin Stabilized by Cellulose Nanocrystals/Chitosan Oligosaccharide: Effect in Promoting Wound Healing. Pharmaceutics. 2024; 16(11):1411. https://doi.org/10.3390/pharmaceutics16111411
Chicago/Turabian StyleXie, Long, Xiaolin Dai, Yuke Li, Yi Cao, Mingyi Shi, and Xiaofang Li. 2024. "Pickering Emulsion of Curcumin Stabilized by Cellulose Nanocrystals/Chitosan Oligosaccharide: Effect in Promoting Wound Healing" Pharmaceutics 16, no. 11: 1411. https://doi.org/10.3390/pharmaceutics16111411
APA StyleXie, L., Dai, X., Li, Y., Cao, Y., Shi, M., & Li, X. (2024). Pickering Emulsion of Curcumin Stabilized by Cellulose Nanocrystals/Chitosan Oligosaccharide: Effect in Promoting Wound Healing. Pharmaceutics, 16(11), 1411. https://doi.org/10.3390/pharmaceutics16111411

